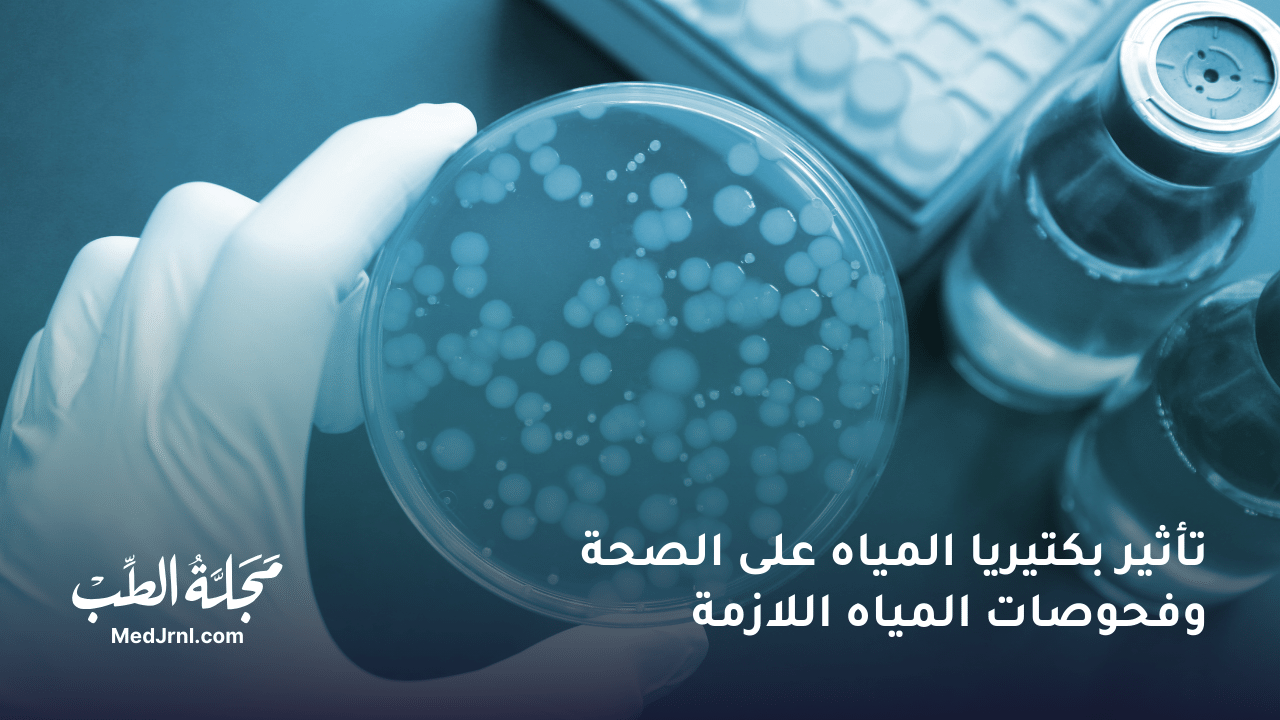

تعد بكتيريا المياه أحد الجوانب المهمة التي تؤثر على حياتنا اليومية وصحتنا. على الرغم من أننا لا نراها بالعين المجردة، إلا أن بكتيريا المياه موجودة في مختلف مصادر المياه التي نستخدمها يوميًا، سواء كان ذلك للاستحمام أو الشرب أو حتى ري النباتات. يمكن أن يكون لبعض أنواع بكتيريا المياه فوائد، في حين أن البعض الآخر يمكن أن يشكل مخاطر صحية جدية. في هذا المقال، سنأخذكم في جولة شاملة حول كل ما يتعلق ببكتيريا المياه، أنواعها، تأثيرها على صحتنا، وأخيرًا، كيفية فحص المياه للتحقق من جودتها وسلامتها.
أنواع البكتيريا الموجودة في المياه
هناك العديد من أنواع البكتيريا التي يمكن أن توجد في الماء، ولكن يمكن تصنيفها بشكل عام إلى نوعين رئيسيين: البكتيريا المفيدة والبكتيريا الضارة.
- البكتيريا المفيدة: تساعد هذه البكتيريا على الحفاظ على توازن النظام البيئي للمياه. فهي تساهم في تحليل المواد العضوية وتدوير العناصر الغذائية. أحد الأمثلة على البكتيريا المفيدة هي بكتيريا النتريفيكانتس (Nitrificans)، والتي تقوم بأكسدة الأمونيا إلى نترات. هذه العملية ضرورية لإزالة الأمونيا السامة من الماء والحفاظ على توازن مستويات الأكسجين.
- البكتيريا الضارة: من ناحية أخرى، يمكن أن تسبب هذه البكتيريا أمراضًا للإنسان والحيوان إذا تم استهلاكها أو التعرض لها. تشمل الأمثلة على البكتيريا الضارة الإشريكية القولونية (E. coli)، والسالمونيلا (Salmonella)، والليستيريا (Listeria). يمكن أن تنتقل هذه البكتيريا إلى الماء من خلال مياه الصرف الصحي أو التلوث البرازي، وعادة ما تشير إلى تلوث المياه بالفضلات البشرية أو الحيوانية.
البكتيريا الضارة
البكتيريا الضارة هي تلك التي يمكن أن تسبب الأمراض والإصابات للبشر والحيوانات. تشمل بعض أنواع البكتيريا الضارة الشائعة الموجودة في المياه ما يلي:
- بكتيريا الإشريكية القولونية (E. coli): يمكن أن تسبب هذه البكتيريا الإسهال، والتسمم الغذائي، والالتهابات الخطيرة. غالبًا ما تكون مؤشرًا على تلوث المياه بالفضلات البشرية أو الحيوانية.
- بكتيريا السالمونيلا: نوع آخر من البكتيريا التي يمكن أن تسبب التسمم الغذائي، وتوجد غالبًا في المياه الملوثة بالبراز.
- بكتيريا الليستيريا: يمكن أن تسبب مرض الليستيريا، وهو مرض خطير خاصة لدى النساء الحوامل، وكبار السن، والأشخاص ذوي الجهاز المناعي الضعيف.
- بكتيريا السيدوموناس: نوع من البكتيريا المقاومة للأدوية والتي يمكن أن تسبب التهابات خطيرة، خاصة لدى الأفراد الذين يعانون من ضعف الجهاز المناعي.
البكتيريا النافعة
البكتيريا النافعة هي تلك التي لها دور مفيد في البيئة أو لصحة الإنسان. على سبيل المثال:
- بكتيريا النتريفيكانتس: هذه البكتيريا تساعد في عملية النترتة، والتي تعتبر جزءًا مهمًا من دورة النيتروجين في الطبيعة.
- البكتيريا الملبنة (Lactobacillus): غالبًا ما توجد في منتجات الألبان المخمرة، مثل اللبن (الزبادي)، ولها فوائد صحية عديدة، بما في ذلك تحسين صحة الجهاز الهضمي وتعزيز جهاز المناعة.
- بكتيريا البروبيونية العدية (Propinibacterium): تستخدم في إنتاج الأجبان، ولها دور في منع نمو البكتيريا الضارة.
بكتيريا المياه الراكدة
بالإضافة إلى هذين النوعين الرئيسيين، هناك أيضًا أنواع محددة من البكتيريا التي يمكن أن توجد في المياه الراكدة أو في أنظمة المياه المعالجة بشكل غير صحيح. تشمل هذه الأنواع:
- بكتيريا الكوليفورم: تشير إلى مجموعة من البكتيريا التي تعيش في أمعاء البشر والحيوانات الدافئة الدم. في حين أن معظم أنواع الكوليفورم غير ضارة، إلا أن وجودها في الماء يشير إلى احتمال تلوث المياه بمسببات الأمراض. غالبًا ما يتم استخدام بكتيريا الكوليفورم كمؤشر على جودة المياه، حيث أن وجودها بكميات كبيرة قد يشير إلى وجود مسببات أمراض أخرى أكثر خطورة.
- السيدوموناس (Pseudomonas): تعد بكتيريا السيدوموناس من البكتيريا الشائعة في البيئة، ويمكن أن توجد في التربة والماء. في حين أن معظم سلالات السيدوموناس غير ضارة، إلا أن بعضها يمكن أن يسبب أمراضًا، خاصة لدى الأفراد الذين يعانون من ضعف في جهاز المناعة. يمكن أن تنتقل بكتيريا السيدوموناس إلى الإنسان من خلال ملامسة المياه الملوثة أو حتى من خلال استنشاق الرذاذ الملوث.
مصادر بكتيريا المياه
يمكن أن تأتي بكتيريا المياه من مصادر مختلفة، بما في ذلك:
- المياه السطحية: مثل الأنهار والبحيرات والخزانات. يمكن أن تحتوي هذه المصادر على بكتيريا من التربة، والنباتات، والحيوانات، وكذلك من التلوث الناتج عن النشاط البشري.
- مياه الصرف الصحي: يمكن أن تحتوي مياه الصرف الصحي على بكتيريا ضارة من الفضلات البشرية والحيوانية. إذا لم تتم معالجة مياه الصرف الصحي بشكل صحيح قبل إطلاقها في البيئة، يمكن أن تلوث مصادر المياه الأخرى.
- المياه الجوفية: يمكن أن تحتوي المياه الجوفية على بكتيريا طبيعية موجودة في التربة والصخور. ومع ذلك، يمكن أيضًا أن تتلوث بالبكتيريا الضارة إذا تسربت مياه الصرف الصحي أو الملوثات الأخرى إلى خزانات المياه الجوفية.
- أنظمة المياه المنزلية: يمكن أن تنمو البكتيريا في أنظمة المياه المنزلية، خاصة إذا كانت الأنابيب أو الخزانات قديمة أو غير نظيفة. يمكن أن تحتوي أجهزة ترشيح المياه أو أجهزة تنقية المياه المنزلية أيضًا على بكتيريا إذا لم يتم صيانتها وتنظيفها بشكل صحيح.
أثر بكتيريا المياه على الصحة
يمكن أن يكون لبكتيريا المياه تأثيرات مختلفة على صحة الإنسان، اعتمادًا على نوع البكتيريا ومدى تعرض الفرد لها. تشمل بعض التأثيرات الشائعة ما يلي:
- أمراض الجهاز الهضمي: هذا هو التأثير الأكثر شيوعًا لتلوث المياه بالبكتيريا. يمكن أن تسبب البكتيريا الضارة، مثل الإشريكية القولونية والسالمونيلا، الإسهال والغثيان وآلام البطن والحمى إذا تم استهلاكها. قد تكون هذه الأعراض خفيفة إلى شديدة، اعتمادًا على كمية البكتيريا المستهلكة وحالة الجهاز المناعي للفرد.
- الالتهابات الجلدية: يمكن أن تسبب بعض أنواع البكتيريا، مثل السيدوموناس، التهابات جلدية إذا تم ملامسة المياه الملوثة. قد تظهر هذه الالتهابات على شكل طفح جلدي أو بثور أو حتى تقرحات. غالبًا ما تكون هذه الالتهابات مؤلمة وقد تتطلب علاجًا طبيًا.
- أمراض الجهاز التنفسي: يمكن أن تدخل بكتيريا المياه إلى الجسم من خلال الاستنشاق، خاصة إذا كان الماء الملوث على شكل رذاذ. يمكن أن تسبب بكتيريا السيدوموناس، على سبيل المثال، التهابات الجهاز التنفسي، خاصة لدى الأفراد المعرضين للخطر.
- الحساسية: في بعض الحالات، يمكن أن تؤدي التعرض لبعض أنواع بكتيريا المياه إلى استجابات تحسسية. قد تشمل الأعراض سيلان الأنف والعطس والحكة في العينين أو الجلد.
- المشاكل العصبية: في حالات نادرة، يمكن أن تسبب بعض أنواع البكتيريا الموجودة في المياه الراكدة أو غير المعالجة بشكل صحيح أمراضًا عصبية. على سبيل المثال، يمكن أن تؤدي بكتيريا السبيروكيتا (Spirochetes) الموجودة في المياه الراكدة إلى الإصابة بمرض التهاب السحايا، وهو مرض خطير يصيب الأغشية المحيطة بالدماغ والنخاع الشوكي.
من المهم أن نلاحظ أن التأثيرات الصحية لبكتيريا المياه يمكن أن تختلف اعتمادًا على عمر الشخص، وحالته الصحية العامة، ومدى تعرضه للبكتيريا. على سبيل المثال، قد يكون الأطفال الصغار، وكبار السن، والأشخاص الذين يعانون من ضعف الجهاز المناعي أكثر عرضة للإصابة بالأمراض المرتبطة ببكتيريا المياه.
فحوصات المياه للتحقق من بكتيريا المياه
هناك عدة طرق لتحليل المياه ميكروبيولوجيًا والتحقق من وجود بكتيريا المياه. تشمل هذه الطرق:
- العدّ الكلي للبكتيريا: يتم أخذ عينة من الماء وخلطها مع وسط مغذي، ثم يتم حساب عدد البكتيريا الموجودة في العينة. يمكن أن يعطي هذا الاختبار مؤشرًا عامًا عن مستوى تلوث المياه بالبكتيريا، ولكن لا يمكنه تحديد أنواع البكتيريا الموجودة.
- فحوصات بكتيريا الكوليفورم: كما ذكرنا سابقًا، تعد بكتيريا الكوليفورم مؤشرًا مهمًا على جودة المياه. هناك عدة طرق لاختبار وجود الكوليفورم، بما في ذلك طريقة الأمعاء المتعددة (MPN) وطريقة الأغار المُبَوَّغ (MUG). تعطي هذه الاختبارات مؤشرًا على احتمال وجود مسببات أمراض أخرى في المياه.
- فحوصات بكتيريا السيدوموناس: يمكن الكشف عن بكتيريا السيدوموناس في الماء باستخدام تقنيات مختلفة، بما في ذلك الزراعة البكتيرية والتفاعل المتسلسل للبوليميراز (PCR). غالبًا ما يتم استخدام هذه الاختبارات في أنظمة المياه المعالجة، مثل أحواض السباحة أو المياه المستخدمة في غسيل الكلى، حيث أن وجود السيدوموناس قد يشكل خطرًا على صحة الأفراد المعرضين.
- فحوصات بكتيريا الاشريكية القولونية (E. coli): تعد بكتيريا E. coli أحد مسببات الأمراض الشائعة التي تشير إلى تلوث المياه بمياه الصرف الصحي. يمكن الكشف عن وجودها باستخدام طرق مختلفة، بما في ذلك الزراعة البكتيرية واختبارات الأنتيجين. غالبًا ما يتم استخدام هذه الاختبارات للتحقق من جودة مياه الشرب أو المياه الترفيهية، مثل مياه البحيرات والأنهار.
- الفحوصات الميكروبيولوجية المتخصصة: قد تكون هناك حاجة إلى فحوصات ميكروبيولوجية أكثر تخصصًا في بعض الحالات، خاصة إذا كان هناك اشتباه في وجود أنواع معينة من البكتيريا. يمكن أن تشمل هذه الفحوصات زراعة البكتيريا، والمجهر الإلكتروني، والتحليل الجيني.
عادة ما يتم أخذ عينات المياه وإرسالها إلى مختبرات متخصصة لإجراء هذه الفحوصات. يمكن أن تساعد نتائج هذه الفحوصات في تحديد مصادر تلوث المياه، وتقييم المخاطر الصحية المحتملة، واتخاذ الإجراءات المناسبة لضمان سلامة المياه.
طرق الوقاية من تلوث المياه بالبكتيريا
لحماية الصحة العامة، يجب اتباع بعض الإجراءات الوقائية للحد من تلوث المياه بالبكتيريا، ومنها:
- تنقية المياه: استخدام المرشحات وأجهزة التنقية التي تعمل بالأشعة فوق البنفسجية يمكن أن يقلل من نسبة البكتيريا في المياه.
- معالجة المياه: معالجة المياه بالكلور أو الأوزون تعد من الطرق الفعالة في قتل البكتيريا والميكروبات الضارة.
- التخزين السليم للمياه: يجب تخزين المياه في حاويات نظيفة ومغلقة لمنع تلوثها بالبكتيريا.
نصائح للوقاية من مخاطر بكتيريا المياه
إليك بعض النصائح التي تقدمها مجلة الطب للوقاية من مخاطر بكتيريا المياه:
- احرص على شرب المياه المعبأة أو المياه التي تم غليها وتبريدها إذا كنت غير متأكد من جودة مصدر المياه.
- حافظ على نظافة خزانات المياه وأنظمة ترشيح المياه في منزلك، وقم بصيانتها بانتظام.
- إذا كنت تستخدم مياه الآبار أو المصادر غير المعالجة، ففكر في تركيب أنظمة تنقية المياه المنزلية الموثوقة.
- عند السباحة في البحيرات أو الأنهار، تجنب ابتلاع الماء، واستحم بعد السباحة للتخلص من أي بكتيريا عالقة على جسمك.
- إذا كنت تعاني من ضعف الجهاز المناعي أو لديك حالة صحية تجعلك أكثر عرضة للإصابة، فاستشر طبيبك بشأن طرق إضافية لحماية نفسك من مخاطر بكتيريا المياه.
نصيحة مجلة الطب
تعد جودة المياه أحد الجوانب المهمة التي تؤثر على صحتنا اليومية. للحفاظ على سلامتك وسلامة عائلتك، من المهم أن تكون على دراية بمصادر مياهك وأن تتخذ الخطوات اللازمة لضمان جودتها. إذا كنت تشك في تلوث مياهك بالبكتيريا، فلا تتردد في إجراء الفحوصات اللازمة واتخاذ الإجراءات التصحيحية. تذكر أن الوقاية خير من العلاج!
آمل أن يكون هذا المقال قد قدم لك نظرة شاملة على عالم بكتيريا المياه. تذكر أن بكتيريا المياه يمكن أن يكون لها تأثير كبير على صحتنا، لذا من المهم أن نكون على دراية بالأنواع المختلفة، وتأثيراتها المحتملة، وكيفية فحص المياه للتحقق من جودتها. من خلال اتباع إرشادات السلامة البسيطة والحرص على فحص مصادر مياهك بانتظام، يمكنك حماية نفسك وعائلتك من المخاطر المحتملة.